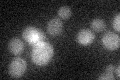
YMR190C
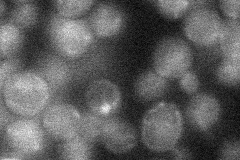
YMR190C
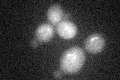
YMR190C

View description
Nucleolar DNA helicase of the RecQ family involved in genome integrity maintenance; regulates chromosome synapsis and meiotic joint molecule/crossover formation; similar to human BLM and WRN proteins implicated in Bloom and Werner syndromes
Localization:
Intensity:
Fold change:
Significance:
-
C’ GFP library in SD
below threshold16.29 -
N' NOP1pr-GFP in SD

punctate,nucleus38.2888 -
N' TEF2pr-mCherry in SD

punctate,nucleus0 -
N' NATIVEpr-GFP in SD
below threshold19.1355 -
N' TEF2pr-VC and Cyto-VN in SD

#N/A0 -
C’ GFP library in SD+DTT
cytosol15.650.96No -
C’ GFP library in SD+H2O2

cytosol19.561.2No -
C’ GFP library in Starvation Media

cytosol16.51.01No -
C’ GFP library on the background of Pup2-DaMP

below threshold -
C’ GFP library on the background of CCT mutant

below threshold16.55521.0157No
